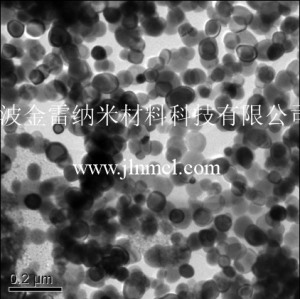
納米銀粉

產品系列

納米銅粉
納米銀粉

納米二氧化鈰

納米氧化釔

氮化鈦

三氧化鉬

納米碳粉

碳化鈦鋁 Ti3AlC2 312結構

碳化鈦鋁 Ti2AlC 211結構

碳化鈦硅 Ti3SiC2 312結構

釩粉

納米錫粉

四氧化三鈷

三氧化鎢

氮化硼

二硫化鎢

二硼化鈦

六硼化鈣

碳化鎢

Delaminated-Ti3C2Tx

氧化釤

氧化鐠

氧化釹

氧化鑭

氧化鈥

氧化釓

氧化鏑

碳化鉭

碳化鈦

碳化硼
新聞資訊

2019-621
銅加工行業發展前景分析
銅加工行業定義銅加工產品可分為銅和銅基合金產品。銅和銅基合金的屬性使其應用于多個領域。銅有良好的可加工性、高導電及導熱性

2019-621
粉末冶金材料的熱處理工藝
您了解嗎?如今粉末冶金材料被應用得越來越廣泛,它們在取代低密度、低硬度和強度的鑄鐵材料方面已經具有明顯優勢。粉末冶金材料

2019-529
銅加工行業發展前景分析
銅加工行業定義銅加工產品可分為銅和銅基合金產品。銅和銅基合金的屬性使其應用于多個領域。銅有良好的可加工性、高導電及導熱性

2019-529
金屬粉末軋制工藝的介紹
金屬粉末軋制是成形工藝中的重要成形手段之一,對于制造金屬薄板、帶材,特別是高孔隙度的多孔薄帶材時,它無疑是一種簡捷的成形

2019-516
金屬粉末性能介紹和制取方法
金屬粉末屬于松散狀物質,其性能綜合反映了金屬本身的性質和單個顆粒的性狀及顆粒群的特性。一般將金屬粉末的性能分為化學性能、
友情鏈接:有機錫化合物 鍋爐清洗廠家 積家維修保養中心




